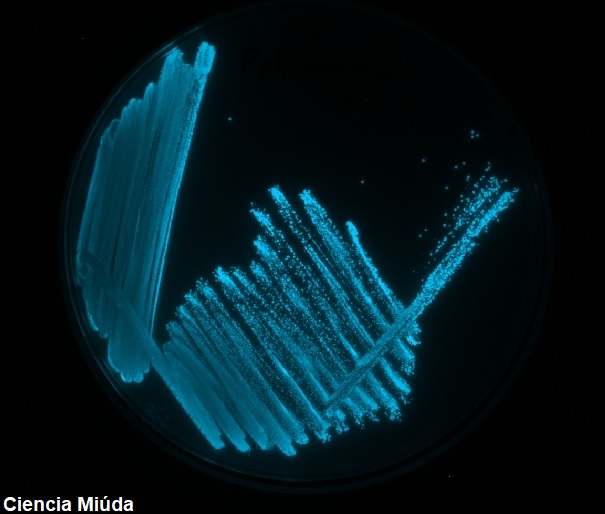

Este artículo tiene un objetivo muy claro. Quiero convencerte no solo de que las bacterias no son aburridas sino de que las bacterias molan (mucho) y pueden hacer cosas increíbles. Quizá te parezca raro este amor que profeso a mis queridas bacterias. Pero no estoy sola… ¿Sabias que incluso tienen su propio museo? Está en Ámterdam y se llama Micropia .

Como probablemente has aprendido durante la pandemia la ciencia es algo que evoluciona muy muy rápido. Así que te puedes hacer una idea de que significan 20 años en el ámbito científico. Así, en este nuevo siglo se han producido avances espectaculares en todos los campos de la ciencia, y por supuesto la microbiología no iba a ser menos.
Ya hace tiempo que los microbiólogos lo sabíamos pero en los últimos años el resto de científicos (y también la población) ha comprendido que los microorganismos son mucho más complejos de lo que puede parecer en un principio. De hecho, desde que se descubrió que muchos microbios son capaces de relacionarse entre ellos cambiando su comportamiento (pasando del sencillo de ser unicelular a una complejidad más característica de seres pluricelulares) surgió una nueva (sub)disciplina científica: la sociomicrobiología bacteriana.
Quorum sensing: la comunicación bacteriana

Las bacterias son capaces comunicarse entre sí para distinguir cuando viven en grupo. Esto les permite cambiar su comportamiento de forma coordinada según sean pocas o muchas viviendo en un mismo sitio. Así las bacterias pueden ponerse de acuerdo para activar o desactivar determinados genes según el tamaño de la población. A esta particular comunicación que depende de la densidad de las bacterias se llama quorum sensing. Se basa en que las bacterias producen unas moléculas que actúan como señales químicas. Las bacterias tienen unos receptores que les permiten «sentir» estas moléculas y saber cuantas células vecinas hay. Estas señales son autoinductoras, es decir, cuantas más moléculas «sienten» las bacterias más producen. Además, cuanto mayor es el número de estas moléculas de quorum sensing significa que más bacterias deben de estar viviendo juntas. De esta forma, cuando la cantidad de la molécula señal llega a una concentración mínima (quorum), las bacterias “saben” que están en comunidad. Todas juntas activan o desactivan determinados genes cambiando su comportamiento para hacer algo a la vez. Este «algo» suele ser un comportamiento que gasta mucha energía y que solo vale la pena cuando lo hacen todas juntas.
La increíble historia de Aliivibrio fisheri y el calamar hawaiano
Te voy a contar mi ejemplo favorito del quorum sensing, aunque que sepas que mola mucho más que te lo cuenten a que lo tengas que leer. Esta es la historia de como el quorum sensing se descubrió por la curiosidad que generaba la increíble relación que hay entre una bacteria marina llamada Aliibrio fisheri (antes Vibrio fisheri) y el calamar hawaiano. Este calamar es un depredador nocturno que vive en las aguas de Hawái, que son aguas muy cristalinas y muy poco profundas. Debido a estas dos características, por las noches la luz de la luna es capaz de llegar hasta cualquier parte del fondo marino. Esto para los depredadores nocturnos es un gran problema: la luz de la luna incide sobre ellos y se produce una sombra que alerta de su presencia a las posibles presas. Sin embargo, esto no le pasa al calamar hawaiano que tiene en su cabeza unos compartimentos en los que por la noche se acumula la bacteria. Curiosamente, la luz producida por esta bacteria bioluminiscente cuando se activan sus genes de quorum sensing tiene exactamente la misma intensidad que la luz de la luna que incide sobre la espalda del calamar. Así, el calamar no produce ninguna sombra que alerte a sus posibles presas y le es mucho más fácil cazar. Durante el día, mientras el calamar duerme, los compartimentos donde se aloja la bacteria están abiertos y al haber pocas bacterias no hay producción de luz.
Aunque esto de que las bacterias se comunican os puede parecer algo nuevo, esta bonita historia es de los años 70. Pero como pasa muchas veces hasta que no se entendió la importancia de entender el comportamiento de las bacterias no se le prestó atención. Comprender como las bacterias se coordinan para ponernos enfermos es importantísimo para poder crear nuevos tratamientos para curar infecciones. Y es que en 30 años habrá un gran problema porque una gran parte de las infecciones bacterianas no se podrán tratar con los antibióticos que tenemos hoy en día. Se calcula que morirá más de infecciones que del mismísimo cáncer. ¿Te imaginas un mundo en el que los antibióticos ya no sirvan?
Si te gusta mi proyecto y te apetece ayudarme un poquito puedes invitarme a un café (ko-fi)
